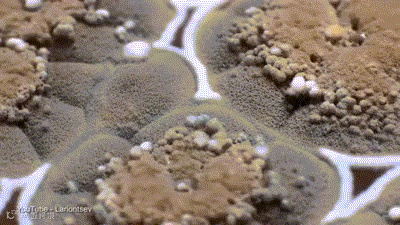

点击蓝字关注我们

7月8日18点,中国气象局发布地质灾害气象风险预警,暴雨橙色预警,山洪灾害气象预警。

全国暴雨预警创近10年连发天数新纪录,今年真的很不平凡......



预计,7月8日20时至9日20时,江西中北部、福建北部、浙江中南部、上海、湖南中部、贵州中南部、广西北部、云南西部和东北部、四川南部以及华北中西部等地有大到暴雨,其中,江西中部偏东地区、浙江西南部、福建西北部、湖南西南部、贵州东南部等地的部分地区有大暴雨,江西东北部等地局地有特大暴雨(250~280毫米)。上述部分地区伴有短时强降水(最大小时降雨量40~60毫米,局地可超过80毫米),局地有雷暴大风等强对流天气。

大家一定要注意安全,提高风险意识,学会避险自救,做到全民防险。

那么,频繁的降雨会使很多地方都变得潮湿,这种情况下,便成了霉菌疯狂生长的环境,极易生长出木霉、青曲霉、黑曲霉、黄曲霉等等。
三大极易滋生霉菌的环境
仓库霉菌
仓库一般比较潮湿阴暗,通风也不好,墙面或者里边的一些木质货架就容易生长霉菌。
图书馆霉菌
图书馆是个开放的地方,如果太潮湿,书上面就容易长霉,同时发出一股臭味,对阅读者造成影响。
生产车间霉菌
生产车间因设备多,离墙近的设备、制冷风机容易产生冷凝水,墙面受潮后就会产生霉菌。
其他区域霉菌
还有我们家的厨房和卫生间,经常和水接触的地方,在遇水受潮后,也很容易滋生霉菌。比如木质橱柜,木质砧板,防水橡胶条等。还有衣柜,鞋柜内的皮质衣服和鞋子,长时间不穿着,也会生长霉菌,散发臭味。

霉菌在日常生活中也很常见,食物没有得到很好的存放就会长霉,如面包、土豆、红薯等,吃了发霉的食物还会中毒。
所以,我们在购买或者存放食物的时候,一定要选择保质期内的和正确的储存食物。
●产品介绍 ●
要想彻底解决发霉问题,就得从源头上阻断霉菌的生长,天佑晶创给你一站式解决方案。

滑动查看更多

JC-85-C皮革专用防霉精华液
一、高效抑制有害细菌,包括革兰氏阳性菌、革兰氏阴性菌。
二、具有广谱和持久的防霉性能:对毛壳霉、绿粘帚霉、绳状青霉、出芽短梗、黄曲霉、黑曲霉等主要有害霉菌的防霉效果达到1级以上。
JC-85-D防霉剂
一、广谱和持久的防霉性能:对霉菌的防霉效果达到1级至0级。不产生耐药性,效果持久。
二、耐水性:本产品不溶于水,可稳定、持久发挥防霉功能。
三、高效安全、性能稳定:具有非常高的安全性,对大鼠经口毒性 LD50>5000mg/Kg,对人体无致癌、致畸和致突变性;不易与其他物质发生化学反应,耐光性好,分解温度大于350℃,不易燃。
JC-85-F防霉剂
一、性能稳定:受pH影响小,本品的防霉效果不易随pH的变化而变化,在pH为3~8范围内均有良好的防霉效果;耐高温,不易氧化变色。
二、添加量少:添加量一般为0.5wt%~1wt%。
三、抑菌范围广:对霉菌、酵母菌和革兰氏阴性菌、阳性菌等微生物均有良好的抑制效果。
四、应用性能好:通过复合工艺,解决了水溶性和分散性问题。
JC-85-G抗菌防霉剂
一、具有安全、高效、广谱和持久的抗菌防霉性能:对青霉菌(嗜松青霉)、球毛壳霉、木霉菌、出芽短梗霉、黑曲霉等主要有害霉菌的防霉效果达到1级及以上;对大肠杆菌和金黄色葡萄球菌的抗菌率均能达到95%以上。
二、溶解度:本产品难溶解于水,溶解于有机溶剂。
JC-85-AS抗菌防霉塑料母粒
一、高效浓缩的广谱抗菌防霉塑料母粒,添加7wt%~9wt%于对应的塑料基体中,对大肠杆菌、金黄色葡萄球菌、沙门氏菌等常见有害细菌的抗菌率达99%以上,对黑曲霉、青霉、出芽短梗霉等霉菌的防霉等级为0级。
二、经专用技术进行分散和母粒化加工,与树脂基体具有良好的分散性和相容性。
三、具有持久、稳定的抗菌防霉效果。
四、使用简便,直接添加,不影响树脂其它性能。

本产品可广泛应用在塑料、橡胶、涂料、医药、纺织、化妆品、皮革、树脂等行业,欢迎有意向的企业和公司垂询。
免责声明:部分文字、配图来源于网络,如有涉及侵权请立即与我们联系,我们将及时删除。
往期推荐



长按识别二维码关注我们












